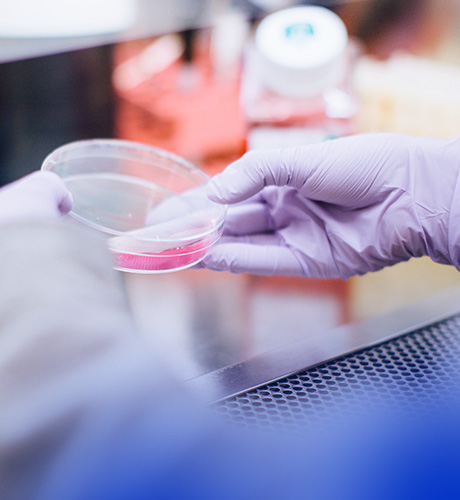

鹏生技术简介
北京鹏生科技有限公司,是一家集认证资质服务,实验室技术服务,政策项目申报服务为一体的专业技术服务机构。
鹏生总部位于北京,在全国拥有6家子公司。鹏生及其旗下子公司的主营业务包括:认证资质服务(认证、认可以及检验)、知识产权服务(商标、版权、专利等)、信息系统服务(软件开发、系统运维、行业CRM等)、实验室技术服务(实验室设计施工、认证认可、设备与运营)以及政策项目申报等服务。鹏生累计服务约8000个国内外品牌客户,客户涵盖环境健康、食品安全、纺织服装、信息安全、医疗器械及工业服务等领域,为众多政府机构、跨国企业和地方大中小客户提供技术服务和支持。
鹏生立足北京,服务全国,在国内建有完善的服务网络,技术人员分部于北京、上海、青岛、苏州、杭州、厦门、深圳等国内主要经济城市。无论客户身在何处,我们实务经验丰富的专家团队均能快速行动,提供更专业的技术解决方案和上门服务。